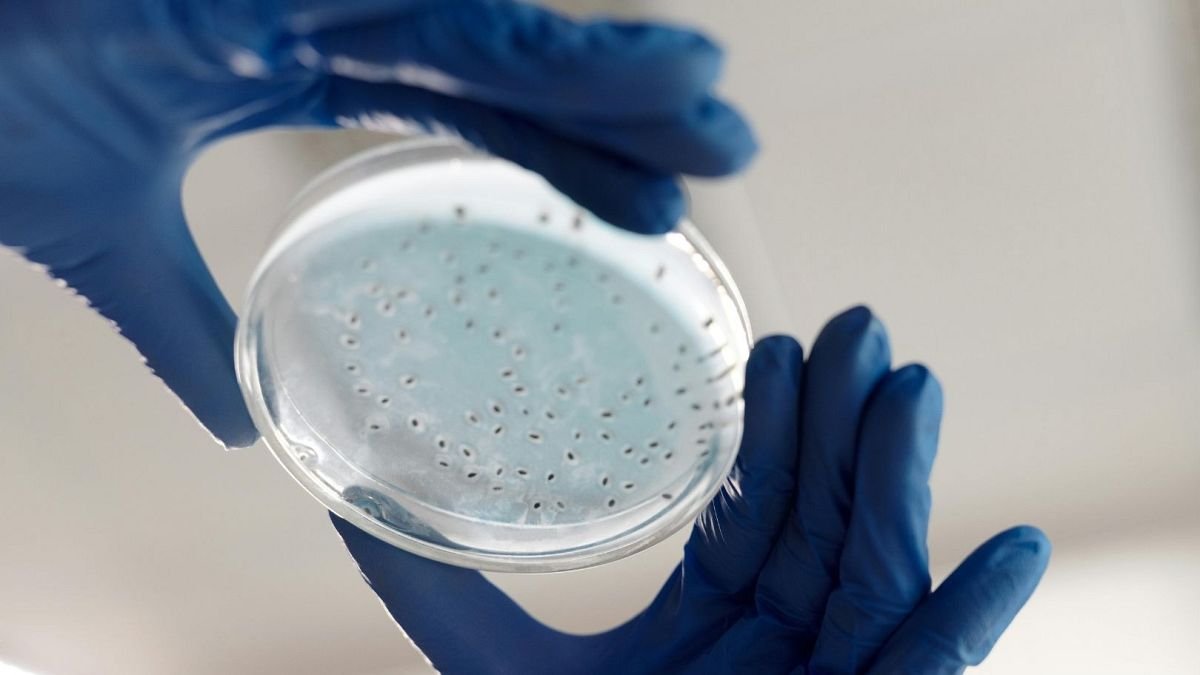

MIT-wetenschappers gebruiken AI voor de ontwikkeling van nieuwe antibiotica tegen hardnekkige gonorroe en MRSA
MIT wetenschappers gebruiken AI voor de ontwikkeling van nieuwe antibiotica tegen hardnekkige gonorroe en MRSA
Wetenschappers hebben kunstmatige intelligentie (AI) gebruikt om potentiële nieuwe medicijnen te creëren voor zogenaamde superbugs – hardnekkige bacteriële infecties die bestaande behandelingen kunnen ontwijken. In de afgelopen jaren heeft AI de ontdekking van medicijnen veranderd, waardoor onderzoekers en farmaceutische bedrijven veelbelovende behandelingen sneller kunnen identificeren door het moeizame proces van het vinden van effectieve verbindingen te versnellen.
Het team van het Massachusetts Institute of Technology (MIT) heeft echter een stap verder gegaan door AI in te zetten om hypothetische chemische moleculen te genereren die nog niet ontdekt zijn of niet bestaan. Hun doel was om volledig nieuwe manieren te vinden om antimicrobiële resistentie aan te pakken, een situatie waarin bacteriën, virussen, schimmels of parasieten zich zodanig ontwikkelen dat de medicijnen die ontworpen zijn om ze te doden niet langer effectief zijn, wat het moeilijker maakt om infecties te behandelen.
Het MIT-team richtte zich op medicijnresistente gonorroe, die door Amerikaanse gezondheidsfunctionarissen wordt aangeduid als een “dringende bedreiging voor de volksgezondheid”, en multi-drug resistente Staphylococcus aureus (MDRSA), waaronder methicilline-resistente Staphylococcus aureus (MRSA) die mensen kunnen oplopen door contact met geïnfecteerde personen of besmet medisch materiaal.
“We wilden alles vermijden wat leek op een bestaand antibioticum, om de crisis van antimicrobiële resistentie (AMR) op een fundamenteel andere manier aan te pakken,” zei Aarti Krishnan, een MIT-onderzoeker en een van de auteurs van de studie, in een verklaring. “Door ons te wagen in onderontgonnen gebieden van de chemische ruimte, was ons doel om nieuwe werkingsmechanismen te onthullen,” voegde Krishnan eraan toe.
Het team gebruikte generatieve AI-algoritmen om meer dan 36 miljoen potentiële verbindingen te creëren en vervolgens de beste kandidaten te vinden om de bacteriën te doden. Ze identificeerden een fragment dat goed leek te werken tegen gonorroe-bacteriën – en na wat extra verfijning ontwikkelden ze twee van deze digitale kandidaten tot daadwerkelijke verbindingen. Een van hen, genaamd NG1, was zeer effectief in het doden van gonorroe-bacteriën in een laboratoriumomgeving en een muismodel.
Na een vergelijkbaar proces om potentiële behandelingen voor MDRSA te vinden, bleken zes moleculen effectief te zijn tegen bacteriën die in een laboratorium waren gekweekt. De onderzoekers gaven aan dat de bevindingen, die zijn gepubliceerd in het tijdschrift Cell, hen kunnen helpen bij het creëren en evalueren van potentiële nieuwe verbindingen gericht op andere bacteriesoorten.
Wereldwijd droegen medicijnresistente bacteriële infecties in 2021 naar schatting bij aan 4,71 miljoen sterfgevallen, en dat cijfer wordt in de komende decennia verwacht te stijgen. “Ons werk toont de kracht van AI vanuit het perspectief van medicijnontwerp en stelt ons in staat om veel grotere chemische ruimtes te benutten die eerder ontoegankelijk waren,” zei James Collins, een MIT-professor en een van de auteurs van de studie, in een verklaring. De wetenschappers werken momenteel samen met Phare Bio, een nonprofit biotechbedrijf, om de verbindingen in het lab verder te testen. Als ze veelbelovend blijven, kunnen deze medicijnkandidaten uiteindelijk in klinische proeven worden getest. “We zijn enthousiast over de nieuwe mogelijkheden die dit project opent voor de ontwikkeling van antibiotica,” zei Collins.